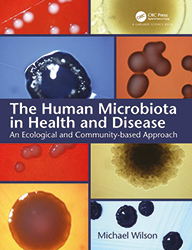
MT-May-19-Reviews-2.jpg

Reviews
The Human Microbiota in Health and Disease: An Ecological and Community-Based Approach
Written by Michael Wilson
CRC Press (2018)
£69.99 ISBN 978-081534585-5
The Human Microbiota in Health and Disease is the first edition of an extraordinary updated academic resource, which provides an exhaustive description on the nature and diversity of the microbial communities inhabiting the human body.
The first two out of 11 chapters introduce the reader to the molecular features of the host–pathogen interactions and the various methods used to investigate the composition of the human microbiota. Here and throughout the text, the book stresses similarities and, most importantly, differences of microbial data obtained through cultivation-dependent and -independent approaches. The following chapters focus deeply on the indigenous microbiota inhabiting the numerous districts of the human body. In detail, each chapter describes: (i) the anatomy and physiology of the body site; (ii) the environmental determinants dictating the composition of the indigenous microbiota; (iii) the metabolic activities and relationships between host cells and microbes which influence and determine the human health; (iv) the involvement of the microbiota in human diseases; (v) the intervention and manipulation of the microbiota that can result in health effects. The book terminates reporting the most recent studies and hypotheses on possible involvements of microbiota in other human diseases and highlighting questions that still need to be answered.
Each chapter is magnificently illustrated, contains several graphic charts and detailed tables, and terminates with a key concept list, review questions and an updated bibliography divided by topics.
Overall, the book is a valuable resource for students, researchers and anyone interested in the human microbiota and its impact in health and disease.
Dr Fabio Giovannercole
Sapienza University of Rome, Italy

Microbiota: Current Research and Emerging Trends
Edited by Takashi Matsumoto and Yoshio Yamaoka
Caister Academic Press (2019)
£159 ISBN: 978-1-910190-93-7
The human microbiome represents an individuals’ unique collection of microbiota, composed from all domains of life (Archaea, Bacteria and Eukarya) which inhabit the human body (microbiota), and their genomic content (microbiome). This short but in-depth book is a collection of insightful peer-reviewed papers which offers a brief insight into the complex relationships between ourselves and our gastrointestinal microbiota. The astute prose summarises the establishment and evolution of the intestinal microbiome, the impact this has during the birthing process – through development into adolescence and ageing, whilst also highlighting the importance of microbial dysbiosis and the influence this exhibits during various disease processes.
The authors describe the dynamic interplay between microbial species, their substrates and metabolites, and the effect these compounds have over both the enteric and central nervous systems, taking the reader on a journey through the early stages of life, including neuronal development and immune system training, through to the natural disruption of microbiota through ageing years and senescence. This approach demonstrates how and why healthy choices affect our well-being throughout our changing lives; however, a mild nuance is that the narrative could have been enhanced by the application of an instinctive timeline. Regardless of this, each chapter covers a new development in modern research, where both the benefits and restrictions of new technologies, including metagenomic and metaproteomic analysis, are well explained, making this book ideal for all interested in the importance of human and microbial interactions. No matter the level of educational achievement, this is a book for undergraduate and adept researcher alike.
Grace Russell
University of the West of England, UK
